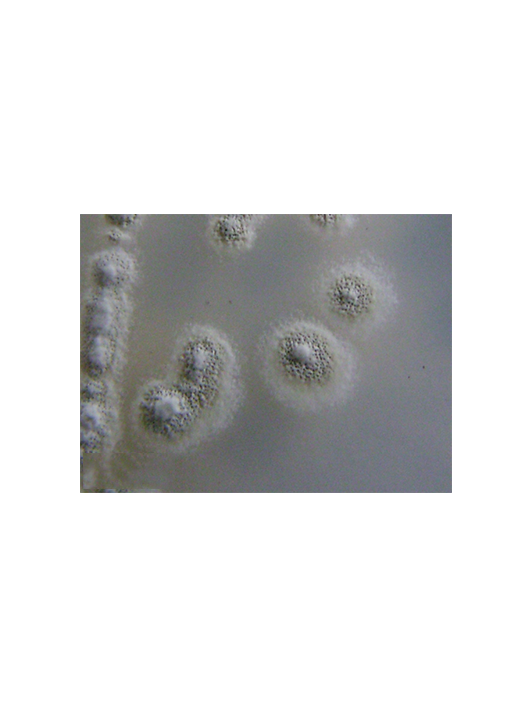
藤黃色鏈霉菌

白地霉
白地霉(Geotrichum candidum)���,菌絲為有橫隔的真菌絲,有的為二叉分枝���。菌絲寬3~7μm���。菌絲成熟后斷裂成單個(gè)或成鏈、長(zhǎng)筒形���、末端鈍圓的節(jié)孢子�。節(jié)孢子大小為4.9~7.6μm×5.4~16.6μm。菌落呈平面擴(kuò)散��,生長(zhǎng)快����,扁平��,乳白色�����,短絨狀或近于粉狀�����,有同心圈可放射線���,有的呈中心突起�����。在液體培養(yǎng)時(shí)生白醭��,毛絨狀或粉狀��。
平面擴(kuò)散
生長(zhǎng)快